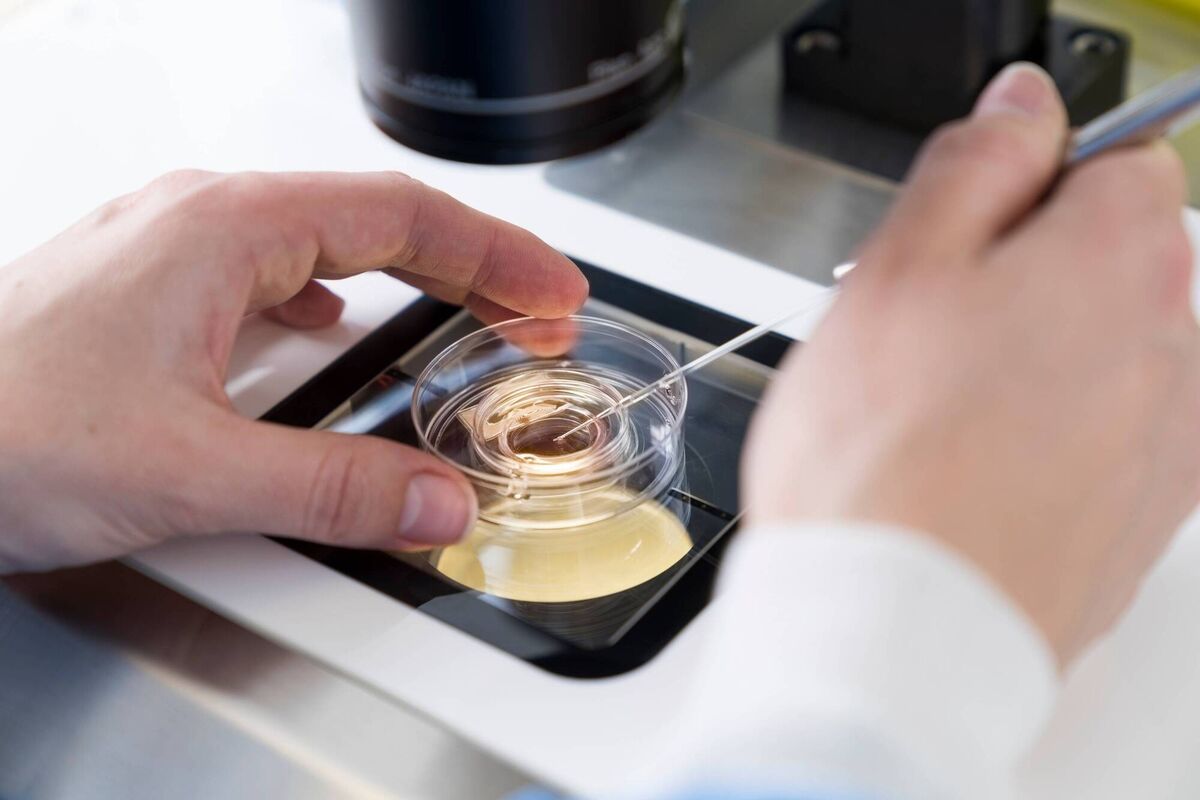

World-class fertility care is available in Cork at the Sims IVF
“We’re born with all the eggs we’re ever going to have,” says Caroline O’Dea, the manager of Sims IVF Cork clinic in Mahon.
"The world of IVF (In vitro fertilisation) came to the fore in the late 1970s," says Caroline O’Dea, the manager of Sims IVF Cork clinic in Mahon.
The clinic is not only local and accessible but also offers world-class fertility care provided by a specialist fertility team that has a track record of success. The clinic is part of Virtus Health, one of the leading global fertility groups based in Australia.
The pioneering work of Sims saw it being the first to introduce many techniques in Ireland, such as advanced fertility testing using techniques like reproductive immunology, sperm DNA fragmentation testing and Anti-Mullerian Hormone (AMH) blood tests.
AMH involves a simple blood test that can determine a woman’s ovarian reserve, or approximately how many eggs a woman has.
“We’re born with all the eggs we’re ever going to have,” says Ms O’Dea.
“Once we hit puberty, we start to release those eggs, and once you’re twenty-five, the count drops. It’s an ever-moving result as such. We say to women in their late twenties and early thirties to have a checkup. We recommend getting your AMH blood tests done around the time your smear is due. There’s a range for your age. If you fall outside of that range, you can have further investigation.”
If a woman is planning to undertake further education or career progression, it’s good to know where she stands in terms of fertility.
“We have some patients for whom, if this information had been available, they might have made different decisions. We are very proactive in educating people. There is always going to be medically indicated infertility. But at a time in your life when you’re making key decisions, it’s all about making people aware.
“Over the last couple of years in this country, we’ve been having really good conversations around mental health and men’s health. We’re getting to the stage now where we can include conversations about fertility. It’s not as taboo as it once was. A lot of people going down the IVF route didn’t want to share that information with family or friends.
"It’s a lot more prevalent in conversation now, and it’s coming from celebrities speaking about it. The stigma attached to IVF is not as topical as it was even five years ago.”
Different patient cohorts attending the Sims clinic in Cork include single women who want their eggs to be frozen and couples who want to bank embryos. “People are deciding to have children later in life because they want to prioritise career and travel, or whatever is important to them.
“There is an increasing number of single women freezing their eggs. Another growing market is same sex couples, with female couples coming in for pregnancy using donor sperm.”
Ms O’Dea has observed that women today are more informed and more empowered. “In women aged between the ages of twenty-five and forty-four, 66% have a third-level qualification. We give our main fertility window to our careers. It’s a critical window for women. People are taking more control of their destiny.”

People who’ve been through IVF often talk about how difficult it was.
“What is anecdotal and based on what we have observed here, and I expect it applies to all clinics, is that you have a couple that have reached out to engage with an IVF clinic. That is not a spur-of-the-moment decision. It would have been a long, long journey to arrive at that point.
"The quest to have a child and start a family can be all-consuming for people. They have to be mindful that IVF is emotionally expensive and financially expensive. Once a couple reaches out to us, they’ve gone through a lot of soul-searching and conversations.”
In the regular menstrual cycle, one dominant egg is released.
“In an IVF cycle, we try to manipulate the cycle so we get a good number of eggs. They are collected transvaginally and brought into the laboratory. The male partner produces a semen sample that’s brought into the lab. The sperm is put in with the eggs, and hopefully fertilised.
"The embryos are put in an incubator that takes photographs of their development. After five days, if there’s a suitable embryo, it will be transferred into the uterus. After two weeks, we do a pregnancy test to see if there’s a viable pregnancy there and then a scan at seven weeks to check that all is going well before the woman either goes to her GP or obstetrician.”
The Sims Clinic always offers counselling to patients. “Some people are quite happy not to engage in counselling. A lot would have already engaged with it as part of the difficult conversations they’ve had when they decide to reach out to a fertility clinic. While we offer one counselling session, some might need more than one.”

For some patients, the transfer of an embryo back into the uterus doesn’t always work the first time. “There might be multiple miscarriages, which isn’t a nice experience for anyone to go through. But there is support available.”
Since marriage equality, Ms O’Dea says more gay couples are seeking out IVF.
“We have a programme called ‘Shared Motherhood’ for same sex couples. One of the partners will provide the egg, which will be fertilised through donor sperm. The other partner will carry the pregnancy. Both have a genetic link to the child. It’s quite a popular programme.”
Ms O’Dea says that her clinic has a large network of research available to its embryologists and doctors. “I think embryo grading and embryo development are probably most significant.”
The Sims Clinic also offers Preimplantation Genetic Testing for Aneuploidy (PGTA). It’s a specialised diagnostic technique that can be used to test embryos for a chromosomal abnormality.
It offers an earlier test than alternative antenatal screening tests. In essence, this test helps identify normal embryos, suitable for transfer (Euploid).
An abnormal embryo shows significant losses or deletions of chromosomes, or an abnormal number of chromosomes in an embryo that is not suitable for transfer (Aneuploid).
For more information, visit www.sims.ie
